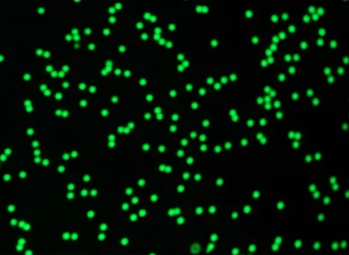

绿色荧光 PLGA 微球 Green fluorescent PLGA microspheres 尺寸可定制 荧光 PLGA 微球,用于 **缓释
| 货号 | 规格 | 数量 | 价格 |
|---|---|---|---|
| Q-0087862 | 100mg |
1
|
询价 |
| Q-0087862 | 250mg |
1
|
询价 |
| Q-0087862 | 500mg |
1
|
询价 |
| Q-0087862 | 1g |
1
|
询价 |
| Q-0087862 | 5g |
1
|
询价 |

FITC标记PLGA微球(100-200nm)
绿色荧光 PLGA 微球
Green fluorescent PLGA microspheres
尺寸可定制
荧光 PLGA 微球,用于 **缓释
乳酸一乙醇酸共聚物Epoly(1actide-co-glycolide),PLGA]作为微球的基体具有低的免疫性、良好的生物相容性及可调控的降解性等优点,因此在**(包括蛋白、多肽、基因等)缓释领域被广泛研究。
NIR 荧光的纳米材料,主要包括半导体量子点和单壁碳纳米管两类。已报道的具有NIR荧光性质的半导体量子点(QD)有CdTe,PbS,PbSe/Te, CdHgTe合金等,它们的主要特点是量子产率高,激发谱宽(可以实现多色激发),Stokes位移大。
纯度:98%
产地:西安
供应商:西安齐岳生物科技有限公司
说明:提供使用说明,核磁图谱,包装,价格,产地,制备方法,应用,稳定性,溶解度,简单合成等各种信息
仅用于科研,不能用于人体试验
| 参数信息 | |
|---|---|
| 外观状态: | 固体或粉末 |
| 质量指标: | 95%+ |
| 溶解条件: | 有机溶剂/水 |
| CAS号: | N/A |
| 分子量: | N/A |
| 储存条件: | -20℃避光保存 |
| 储存时间: | 1年 |
| 运输条件: | 室温2周 |
| 生产厂家: | 西安齐岳生物科技有限公司 |
-
Fluorescent DOTAP 是将常用阳离子脂质 DOTAP(1,2-二油酰-3-三甲基氨基丙基胆碱)偶联荧光染料形成的衍生物。
-
S1P Lyase Fluorogenic Substrate 是专门设计用于检测 S1P 裂解酶(Sphingosine-1-Phosphate Lyase, S1PL)活性的荧光底物。
-
西安齐岳生物提供FITC-, Biotin-, 5-Fam-, Dansyl, TMR(TAMRA)标记各种氨基酸
-
西安齐岳生物提供300多种肽修饰服务,包括 氨基化,乙酰化,甲酰化,生物素,FITC标记多肽,二硫键,磷酸化,KLH,BSA等




 17778955912
17778955912 1521565887
1521565887 1521565887@qq.com
1521565887@qq.com 官方微信
官方微信 官方微博
官方微博